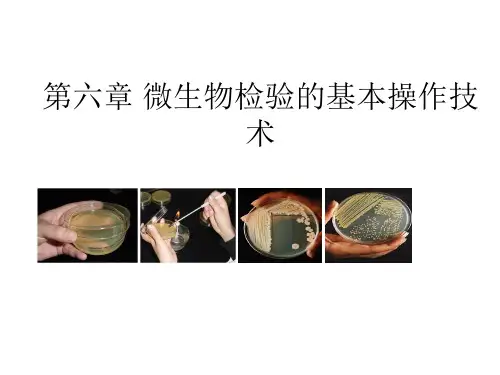

微生物学基本操作技术优秀课件
- 格式:ppt
- 大小:6.05 MB
- 文档页数:95


微生物检验的基本操作技术一、无菌操作技术1、定义是指在执行实验过程中,防止一切微生物侵入机体和保持无菌物品及无菌区域不被污染的操作技术和管理方法;无菌操作技术是微生物实验的基本技术,是保证微生物实验准确和顺利完成的重要环节。
2、内容无菌操作技术主要包括两方面:1)创造无菌的培养环境。
包括提供密闭的培养容器、培养容器的灭菌、培养基的灭菌等;2)在操作和培养过程中防止一切其它微生物的侵入的措施。
包括紫外线杀菌、甲醛熏蒸、超净台的消毒与检测、操作工具、器皿灭菌、操作方法等。
3、无菌操作原则1)在执行无菌操作时,必须明确物品的无菌区和非无菌区,接种时必须穿工作服、戴工作帽,应在进无菌室前用肥皂洗手,然后用75%酒精棉球将手擦干净;2)在操作前20~30分钟要先启动超净台和紫外灯,进行接种所用的吸管、平皿及培养基等必须经消毒灭菌,打开包装未使用完的器皿,不能放置后再使用,金属用具应高压灭菌或用95%酒精点燃烧灼3次后使用。
严禁用手直接拿无菌物品,如瓶塞等,而必须用消毒的钳、镊子等;3)从包装中取出吸管时,吸管尖部不能触及外露部位,使用吸管接种于试管或平皿时,吸管尖不能触及试管或平皿边;4)接种样品、转种细菌必须在酒精灯前操作,接种细菌或样品时,吸管从包装中取出后及打开试管塞都要通过火焰消毒;5)接种环或接种针在接种细菌前应经火焰烧灼全部金属丝,必须时还要烧到环和针与杆的连接处;6)吸管吸取菌液或样品时,应用相应的橡皮头吸取,不得直接用口吸。
倾倒平板应在超净台内操作,并且在开启和加盖瓶塞时需反复用酒精灯烧。
二、无菌操作的环境要求1、无菌室(1)无菌室的结构:更衣间、缓冲间、操作间;(2)无菌室的消毒和防污染•每日(使用前)紫外线照射(0.5~1小时);•每月用新洁尔灭擦拭地面和墙壁一次的方式进行消毒;•每季度用甲醛、乳酸、过氧乙酸熏蒸(2小时),特殊情况下可增加熏蒸频次。
(3)无菌室使用要求①无菌室内应保持清洁,工作后用2%-3%煤酚皂溶液消毒,拭擦工作台面,不得存放与实验无关的物品;②无菌室使用前后应将门关紧,打开紫外线,如采用室内悬吊紫外灯消毒时,需30W紫外灯,距离在1.0m处,照射时间不少于30min,使用紫外灯,应注意不得直接在紫外线下操作,以免引起损伤,灯管每隔两周需用酒精棉球轻轻拭擦,除去上面灰尘和油垢,以减少紫外线穿透的影响;③处理和接种食品标本时,进入无菌室操作,不得随意出入,如需要传递物品,可通过小窗传递。

微生物培养及实验基本操作技术一、培养基配制培养基是指人工配制的、适合于微生物生长繁殖或累积代谢产物所需的各种营养物的混合基质。
配制培养基是进行微生物检验工作的基础,甚至是任何与微生物有关工作的基础。
注意事項–灭菌锅的使用①加水盖过底部铁板—②放入东西—③关门—④調整溫度時間—⑤关紧泄压阀灭菌結束後,等压力降回零時才可打開門進入灭菌锅之物品,蓋子不可關太緊或太鬆拿滅菌後物品請記得帶耐熱手套培养基中的主要成分及其作用:营养物质:N源、C源、无机盐、生长因子、水常用的N源:蛋白胨、牛肉膏、肉浸汁、酵母膏常用的C源:糖、醇类物质(单糖:葡萄糖、果糖、半乳糖、甘露糖双糖:蔗糖、麦芽糖、乳糖;多糖:淀粉、纤维素、菊糖;醇类:甘露醇、卫茅醇、甘油)水:用蒸馏水,不能用自来水凝固剂:琼脂、明胶、血清等抑制剂:1、作用:鉴定细菌、抑制杂菌的生长繁殖,增加待检菌的检出率2、种类:盐类:氯化钠、氯化锂、氰化钾、亚碲酸钾(钠)、亚硒酸钠等染色剂类:煌绿、蔷薇酸、结晶紫、孔雀绿、孟加拉红、玫瑰红胆盐类:猪(牛、羊)胆盐、混合胆盐、三号胆盐、去氧胆酸盐、胆石酸盐抗菌素:青霉素、链霉素、杆菌肽、多粘菌素指示剂1、作用:用于指示鉴别细菌可否利用分解糖醇类物质和含氮化合物,产酸产碱的能力。
2、常用的指示剂:酚红、溴甲酚紫、中性红、中国蓝、甲基红、复红、伊红、美蓝、孔雀绿等。
培养基的类型:●根据培养基的物理状态来区分:1、液体培养基:主要用于增菌培养、鉴别性培养2、固体培养基:用作微生物的分离、鉴定、检验杂菌、计数、保藏、生物测定3、半固体培养基:观察微生物的动力,有时用来保藏菌种4、脱水(商品)培荞基:脱水培养基也称为商品培养基、预制干燥培养基。
●将各种营养成分按比例配制完全,制成脱水的干粉状,装瓶出售;使用时只需按比例加人定量的水溶化、灭菌便可。
●根据培养基的用途来区分:➢增殖培养基选择培养基鉴别培养基1、增殖培养基:在普通培养基中加入一些某种微生物特别喜欢的营养物质,以增加这种微生物的繁殖速度,逐渐淘汰其它微生物,这种培养基称为增殖培养基。